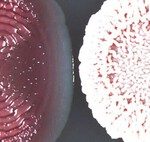

Elton John sigue rockeando: publicó “Who Believes In Angels?” junto a Brandi Carlile
Elton John publicó el disco «Who Believes In Angels?», («¿Quién cree en ángeles?«), un trabajo junto a Brandi Carlile. Días atrás, los protagonistas presentaron algunas de las nuevas canciones en vivo en el London Palladium y que se emitirán en los próximos días. Uno de los temas que trae el álbum es “Little Richard’s Bible” que habla sobre la leyenda del…